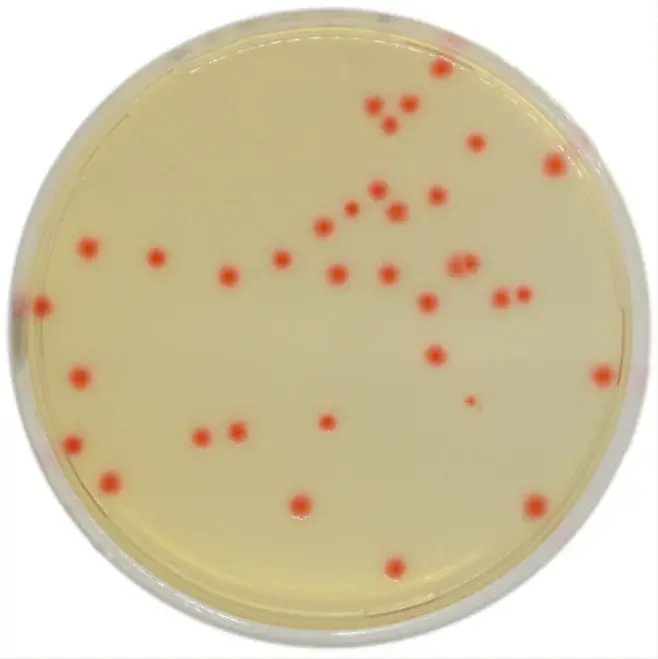
Chromagar C.perfringens 10 Adet

Chromagar C.perfringens 10 Adet
667,12 TL
*68,46 TL den başlayan taksitlerle!
CHROMagar C.perfringens 10 Adet, mikrobiyoloji laboratuvarlarında kullanılmak üzere özel olarak formüle edilmiş bir hazır besiyeridir. CHROMagar markasının güvencesiyle sunulan bu ürün, Clostridium perfringens bakterisinin seçici izolasyonu için ideal bir çözümdür.
Özellikleri:
- Özel formülasyonu sayesinde Clostridium perfringens'in kolayca izole edilmesini sağlar.
- 10 adet içeren paket, laboratuvarınızın ihtiyaçlarını karşılamak için idealdir.
- Kullanımı kolaydır ve sonuçların hızlı bir şekilde elde edilmesini sağlar.
- Kaliteli materyallerden üretilmiştir ve güvenilir sonuçlar almanızı sağlar.
Mikrobiyoloji alanında uzmanlaşmış bir ekip tarafından geliştirilen CHROMagar C.perfringens 10 Adet, laboratuvarınızın ihtiyaç duyduğu doğru ve güvenilir sonuçları elde etmenize yardımcı olacaktır.
Bu ürüne ilk yorumu siz yapın!